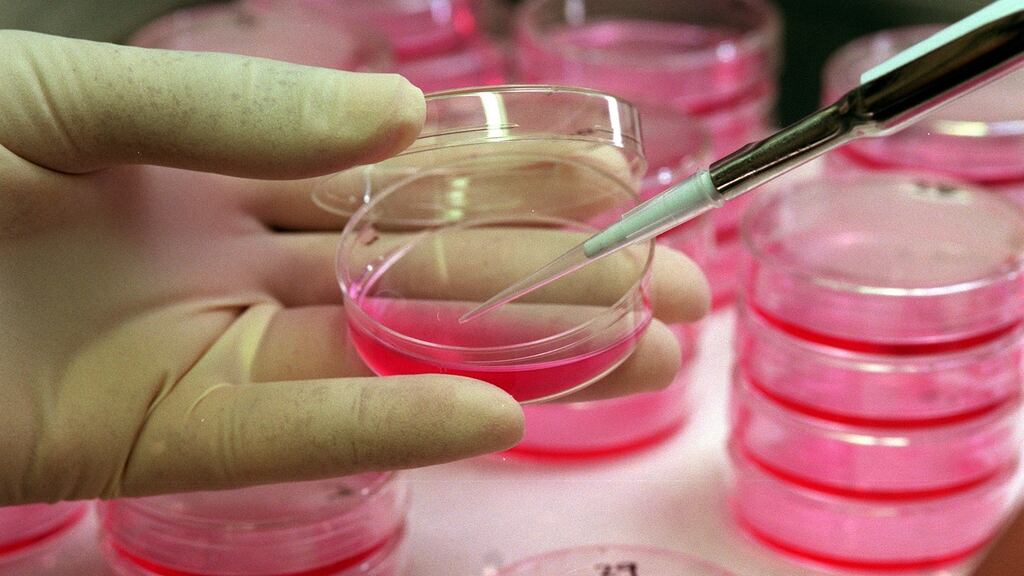
The Positive project aims to provide solid data to aid women in making the choice of whether to disrupt treatment in order to achieve conception. Photograph: Lyn Alweis/The Denver Post/Getty Images)

Irish women are to be involved in a ground-breaking new study which will explore the relationship between breast cancer treatment and pregnancy.
The international research will involve 500 participants from Europe, the US and Australia, with 30 Irish women set to be in the group after Cancer Trials Ireland lobbied for part of the study to be conducted in this country.
Called the Positive trial, it will seek to establish the risks for young female breast cancer survivors who disrupt their course of Tamoxifen, a hormone treatment, in order to have a child.
Used as a follow-up treatment to prevent the recurrence of cancer cells, the hormone course, which usually takes between five and 10 years to complete, prevents conception.
Some women in their 20s, 30s and 40s choose to take a break in order to get pregnant, but consultant medical oncologist Cathy Kelly says the full consequences of disrupting and resuming the treatment for childbirth remain unknown.
"The question being asked here is would it be safe for some of them to have a break during that five years . . . Could they potentially be at a higher risk of recurrence or how much benefit have they foregone by having an interruption of their Tamoxifen?" said Dr Kelly, who leads the study in Ireland, told The Irish Times.
Scientific evidence
“The best available evidence, based on reviewing records retrospectively, suggests that in certain instances pregnancy after breast cancer does not negatively impact disease outcome and is safe for the baby.
“But we really need to have real-time scientific evidence to confirm this and this study will give us that evidence, and hopefully be invaluable for future generations of women in this situation.”
Cancer Trials Ireland is actively seeking to recruit female volunteers aged under 42 who have completed between 18 and 30 months of hormone treatment, but want to take a two-year break in order to become pregnant.
Irish medical facilities involved in the study include the Mater Misericordiae University Hospital, Mater Private and St Vincent's University Hospital as well as hospitals in Galway, Limerick, Cork and Waterford.
The Positive project has a long-term emphasis, with women enrolled over the course of four years for a study that will take 14 years to complete.
It is hoped that the final results will provide solid data to aid women in making the choice of whether or not to disrupt treatment in order to achieve conception.
Almost 700 people die from breast cancer each year in Ireland, and up to one in eight women will be diagnosed with the disease over the course of their lifetime.
According to Dr Kelly, up to 300 women of child-bearing age are diagnosed with breast cancer every year in Ireland.